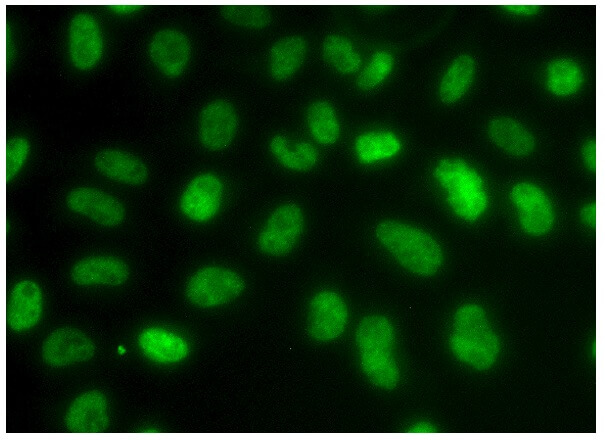
あ　H I F HIF1a抗体(28b) | SCBT - Santa Cruz Biotechnology

マイストア
変更
お店で受け取る
(送料無料)
配送する
納期目安:
2025.12.17 0:12頃のお届け予定です。
決済方法が、クレジット、代金引換の場合に限ります。その他の決済方法の場合はこちらをご確認ください。
※土・日・祝日の注文の場合や在庫状況によって、商品のお届けにお時間をいただく場合がございます。
あ H I F HIF1a抗体(28b) | SCBT - Santa Cruz Biotechnologyの詳細情報
HIF1a抗体(28b) | SCBT - Santa Cruz Biotechnology。トヨタ 純正 マニュアル 5速 トランス ミッション R154 JZX110 33030。PGS HD FORMULA R154用 強化ドグミッショ ギヤセット ギヤ比:2.94。THE MONSTERS PIN FOR LOVE シリーズぬいぐるみペンダント(A-M)出品内容 I種類確認のため開封しただけです。ポップマート正規品なんば店にて購入すり替え防止の為、購入後のキャンセル、返品、交換等お断りさせていただきます!ゆうパケットポストで発送しますポプマポップマートザ モンスターズラブブ新作ミニラブブ イニシャル アルファベット正規品 THE MONSTERS PIN FOR LOVE ぬいぐるみシリーズ Labubuピース ぬいぐるみ ペンダント ブラインドボックスPOP MARTイニシャルラブブアルファベットラブブ。。お箱はたたんで同梱します。ゆうみ様 專用ページ ファイノン
ベストセラーランキングです
近くの売り場の商品
カスタマーレビュー
オススメ度 4.3点
現在、5083件のレビューが投稿されています。




















